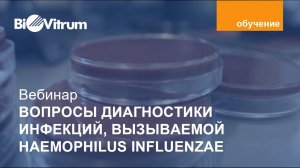
Актуальные вопросы диагностики инфекции вызываемой Haemophilus Influenzae

1:05:59
1:05:59
2024-08-12 11:33

 4:25
4:25

 4:25
4:25
2024-08-08 16:33

 4:30
4:30

 4:30
4:30
2024-08-06 13:07

 19:12
19:12

 19:12
19:12
2025-09-11 14:41

 34:56
34:56

 34:56
34:56
2025-09-12 16:44

 27:58
27:58

 27:58
27:58
2025-09-20 10:00

 7:19
7:19

 7:19
7:19
2025-09-24 15:35

 8:30
8:30

 8:30
8:30
2025-09-12 15:00

 2:15
2:15

 2:15
2:15
2025-09-25 22:19

 1:23:24
1:23:24

 1:23:24
1:23:24
2025-09-18 12:00

 3:20
3:20

 3:20
3:20
2025-09-11 10:37

 1:57:38
1:57:38

 1:57:38
1:57:38
2025-09-15 15:22

 10:29
10:29

 10:29
10:29
2025-09-22 09:39
![Самые жестокие завоеватели в истории? / [История по Чёрному]](https://pic.rutubelist.ru/video/2025-09-22/8f/5b/8f5b92672e89625eec19c110dbe923b0.jpg?width=300)
 55:14
55:14
![Самые жестокие завоеватели в истории? / [История по Чёрному]](https://pic.rutubelist.ru/video/2025-09-22/8f/5b/8f5b92672e89625eec19c110dbe923b0.jpg?width=300)
 55:14
55:14
2025-09-23 12:00

 16:17
16:17

 16:17
16:17
2025-09-17 18:32

 1:50:16
1:50:16

 1:50:16
1:50:16
2025-09-15 14:19

 4:18
4:18

 4:18
4:18
2025-09-21 11:49

 5:52
5:52
![АКУЛИЧ - Красные глаза (Премьера клипа 2025)]() 2:13
2:13
![Леся Кир - Альфонс (Премьера клипа 2025)]() 3:23
3:23
![Маша Шейх - Будь человеком (Премьера клипа 2025)]() 2:41
2:41
![Бунёд Бобокулов - Отам-онам (Премьера клипа 2025)]() 4:00
4:00
![Ольга Стельмах – Не будем всё усложнять (Премьера клипа 2025)]() 4:01
4:01
![Аброр Киличов - Тим-Тим (Премьера клипа 2025)]() 4:42
4:42
![ZAMA - Глаза цвета кофе (Премьера клипа 2025)]() 2:57
2:57
![Хушнуд - Бевафо ёр (Премьера клипа 2025)]() 5:39
5:39
![Женя Белоусова - Раненая птица (Премьера клипа 2025)]() 2:47
2:47
![Tural Everest, Руслан Добрый - Красивая (Премьера клипа 2025)]() 3:16
3:16
![UMARO - 1-2-3 (Премьера клипа 2025)]() 2:52
2:52
![POLAT - Лунная (Премьера клипа 2025)]() 2:34
2:34
![Фрося - На столике (Премьера клипа 2025)]() 1:42
1:42
![ARTEE - Ты моя (Премьера клипа 2025)]() 3:31
3:31
![KhaliF - Я розы тебе принес (Премьера клипа 2025)]() 2:06
2:06
![Даша Эпова - Мой любимый человек (Премьера клипа 2025)]() 2:11
2:11
![NAIMAN - Плакала (Премьера клипа 2025)]() 2:21
2:21
![Абрикоса, GOSHU - Удали из памяти (Премьера клипа 2025)]() 4:59
4:59
![Инна Вальтер - Татарский взгляд (Премьера клипа 2025)]() 3:14
3:14
![Бекзод Хаккиев - Айтаман (Премьера клипа 2025)]() 2:41
2:41
![Большой куш / Спи#дили | Snatch (2000) (Гоблин)]() 1:42:50
1:42:50
![Гедда | Hedda (2025)]() 1:48:23
1:48:23
![Французский любовник | French Lover (2025)]() 2:02:20
2:02:20
![Заклятие 4: Последний обряд | The Conjuring: Last Rites (2025)]() 2:15:54
2:15:54
![Плохой Санта 2 | Bad Santa 2 (2016) (Гоблин)]() 1:34:55
1:34:55
![Только ты | All of You (2025)]() 1:38:22
1:38:22
![Девушка из каюты №10 | The Woman in Cabin 10 (2025)]() 1:35:11
1:35:11
![Протокол выхода | Exit Protocol (2025)]() 1:24:45
1:24:45
![Пойман с поличным | Caught Stealing (2025)]() 1:46:45
1:46:45
![Код 3 | Code 3 (2025)]() 1:39:56
1:39:56
![Бешеные псы | Reservoir Dogs (1991) (Гоблин)]() 1:39:10
1:39:10
![Богомол | Samagwi (2025)]() 1:53:29
1:53:29
![Чумовая пятница 2 | Freakier Friday (2025)]() 1:50:38
1:50:38
![Отчаянный | Desperado (1995) (Гоблин)]() 1:40:18
1:40:18
![Однажды в Ирландии | The Guard (2011) (Гоблин)]() 1:32:16
1:32:16
![Франкенштейн | Frankenstein (2025)]() 2:32:29
2:32:29
![Все дьяволы здесь | All the Devils are Here (2025)]() 1:31:39
1:31:39
![Фантастическая четвёрка: Первые шаги | The Fantastic Four: First Steps (2025)]() 1:54:40
1:54:40
![Трон: Арес | Tron: Ares (2025)]() 1:52:27
1:52:27
![Только во сне | In Your Dreams (2025)]() 1:31:16
1:31:16
![Сборники «Оранжевая корова»]() 1:05:15
1:05:15
![Корги по имени Моко. Новый питомец]() 3:28
3:28
![Пакман в мире привидений]() 21:37
21:37
![Агент 203]() 21:08
21:08
![Хвостатые песенки]() 7:00
7:00
![Простоквашино]() 6:48
6:48
![Неодети]() 11:27
11:27
![Псэмми. Пять детей и волшебство Сезон 1]() 12:17
12:17
![Артур и дети круглого стола]() 11:22
11:22
![Корги по имени Моко. Домашние животные]() 1:13
1:13
![Крутиксы]() 11:00
11:00
![Умка]() 7:11
7:11
![Минифорс. Сила динозавров]() 12:51
12:51
![Панда и Антилопа]() 12:08
12:08
![Тодли Великолепный!]() 3:15
3:15
![Супер Дино]() 12:41
12:41
![Новое ПРОСТОКВАШИНО]() 6:30
6:30
![Лудлвилль]() 7:09
7:09
![Простоквашино. Финансовая грамотность]() 3:27
3:27
![Сборники «Приключения Пети и Волка»]() 1:50:38
1:50:38

 5:52
5:52Скачать Видео с Рутуба / RuTube
| 256x144 | ||
| 432x232 | ||
| 640x360 | ||
| 856x480 | ||
| 1280x720 |
 2:13
2:13
2025-11-15 12:35
 3:23
3:23
2025-11-19 11:51
 2:41
2:41
2025-11-12 12:48
 4:00
4:00
2025-11-21 13:29
 4:01
4:01
2025-11-21 13:05
 4:42
4:42
2025-11-17 14:30
 2:57
2:57
2025-11-13 11:03
 5:39
5:39
2025-11-23 13:40
 2:47
2:47
2025-11-11 17:49
 3:16
3:16
2025-11-12 12:12
 2:52
2:52
2025-11-14 12:21
 2:34
2:34
2025-11-21 13:26
 1:42
1:42
2025-11-12 12:55
 3:31
3:31
2025-11-14 19:59
 2:06
2:06
2025-11-11 18:00
 2:11
2:11
2025-11-15 12:28
 2:21
2:21
2025-11-18 12:25
 4:59
4:59
2025-11-15 12:21
 3:14
3:14
2025-11-18 11:36
 2:41
2:41
2025-11-17 14:22
0/0
 1:42:50
1:42:50
2025-09-23 22:53
 1:48:23
1:48:23
2025-11-05 19:47
 2:02:20
2:02:20
2025-10-01 12:06
 2:15:54
2:15:54
2025-10-13 19:02
 1:34:55
1:34:55
2025-09-23 22:53
 1:38:22
1:38:22
2025-10-01 12:16
 1:35:11
1:35:11
2025-10-13 12:06
 1:24:45
1:24:45
2025-11-13 23:26
 1:46:45
1:46:45
2025-10-02 20:45
 1:39:56
1:39:56
2025-10-02 20:46
 1:39:10
1:39:10
2025-09-23 22:53
 1:53:29
1:53:29
2025-10-01 12:06
 1:50:38
1:50:38
2025-10-16 16:08
 1:40:18
1:40:18
2025-09-23 22:53
 1:32:16
1:32:16
2025-09-23 22:53
 2:32:29
2:32:29
2025-11-17 11:22
 1:31:39
1:31:39
2025-10-02 20:46
 1:54:40
1:54:40
2025-09-24 11:35
 1:52:27
1:52:27
2025-11-06 18:12
 1:31:16
1:31:16
2025-11-21 20:18
0/0
 1:05:15
1:05:15
2025-09-30 13:45
 3:28
3:28
2025-01-09 17:01
 21:37
21:37
2024-11-28 17:35
 21:08
21:08
2025-01-09 16:39
 7:00
7:00
2025-06-01 11:15
 6:48
6:48
2025-10-17 10:00
 11:27
11:27
2025-10-10 18:25
2021-09-22 22:23
 11:22
11:22
2023-05-11 14:51
 1:13
1:13
2024-11-29 14:40
 11:00
11:00
2022-07-25 18:59
 7:11
7:11
2025-01-13 11:05
 12:51
12:51
2024-11-27 16:39
 12:08
12:08
2025-06-10 14:59
 3:15
3:15
2025-06-10 13:56
 12:41
12:41
2024-11-28 12:54
 6:30
6:30
2018-04-03 10:35
 7:09
7:09
2023-07-06 19:20
 3:27
3:27
2024-12-07 11:00
 1:50:38
1:50:38
2025-10-29 16:37
0/0

